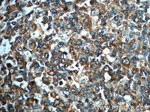
IMPDH1 Antibody in Immunohistochemistry (Paraffin) (IHC (P))

Search
Proteintech
IMPDH1 Polyclonal Antibody
{{$productOrderCtrl.translations['antibody.pdp.commerceCard.promotion.promotions']}}
{{$productOrderCtrl.translations['antibody.pdp.commerceCard.promotion.viewpromo']}}
{{$productOrderCtrl.translations['antibody.pdp.commerceCard.promotion.promocode']}}: {{promo.promoCode}} {{promo.promoTitle}} {{promo.promoDescription}}. {{$productOrderCtrl.translations['antibody.pdp.commerceCard.promotion.learnmore']}}
产品信息
22092-1-AP
种属反应
已发表种属
宿主/亚型
分类
类型
抗原
偶联物
形式
浓度
规格
纯化类型
保存液
内含物
保存条件
运输条件
产品详细信息
Immunogen sequence: LSPSHTVGD VLEAKMRHGF SGIPITETGT MGSKLVGIVT SRDIDFLAEK DHTTLLSEVM TPRIELV (170-235 aa encoded by BC033622 )
靶标信息
The protein encoded by this gene acts as a homotetramer to regulate cell growth. The encoded protein is an enzyme that catalyzes the synthesis of xanthine monophosphate (XMP) from inosine-5'-monophosphate (IMP). This is the rate-limiting step in the de novo synthesis of guanine nucleotides. Defects in this gene are a cause of retinitis pigmentosa type 10 (RP10). Several transcript variants encoding different isoforms have been found for this gene.
仅用于科研。不用于诊断过程。未经明确授权不得转售。
生物信息学
蛋白别名: DKFZp781N0678; IMP (inosine 5'-monophosphate) dehydrogenase 1; IMP (inosine monophosphate) dehydrogenase 1; IMP dehydrogenase 1; IMP dehydrogenase 1 {ECO:0000255|HAMAP-Rule:MF_03156}; IMP dehydrogenase type 1 (EC 1.1.1.205); IMPD 1; IMPD 1 {ECO:0000255|HAMAP-Rule:MF_03156}; IMPDH 1; IMPDH 1 {ECO:0000255|HAMAP-Rule:MF_03156}; IMPDH-I; inosine 5'-phosphate dehydrogenase 1; inosine monophosphate dehydrogenase 1; Inosine-5'-monophosphate dehydrogenase 1; inosine-5'-monophosphate dehydrogenase 1 {ECO:0000255|HAMAP-Rule:MF_03156}; unnamed protein product
基因别名: B930086D20Rik; IMPD; IMPD 1; IMPD1; IMPDH 1; IMPDH-I; IMPDH1; LCA11; RP10; sWSS2608
UniProt ID: (Human) P20839, (Rat) D3ZLZ7, (Mouse) P50096
Entrez Gene ID: (Human) 3614, (Rat) 362329, (Mouse) 23917